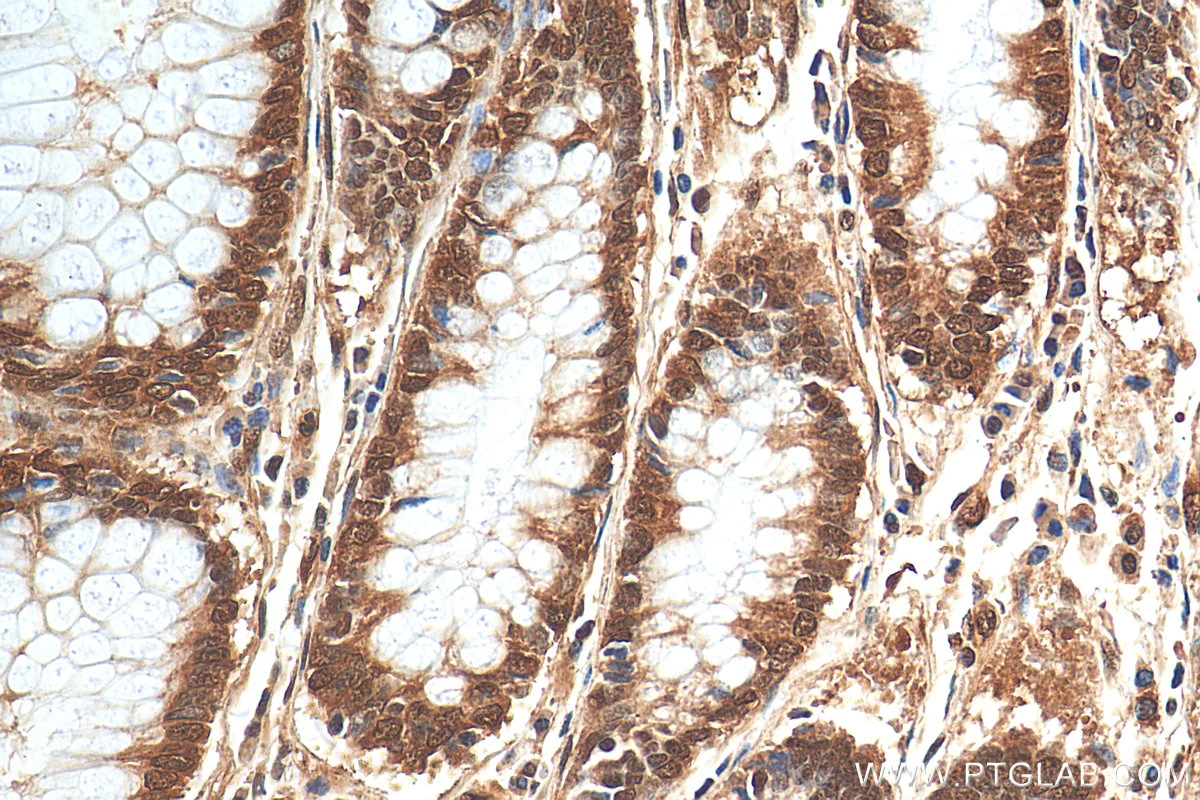
Immunohistochemistry: STAT6

تفاصيل التحليل
تحليل الكيمياء النسيجية المناعية لبروتين (STAT6)
فحص دقيق لبروتين STAT6 لتأكيد تشخيص الأورام الليفية المنفردة النادرة، مما يساعد في تمييزها عن الأورام المشابهة وتحديد العلاج المناسب بدقة.
الصورة التوضيحية المرتبطة بهذا التحليل